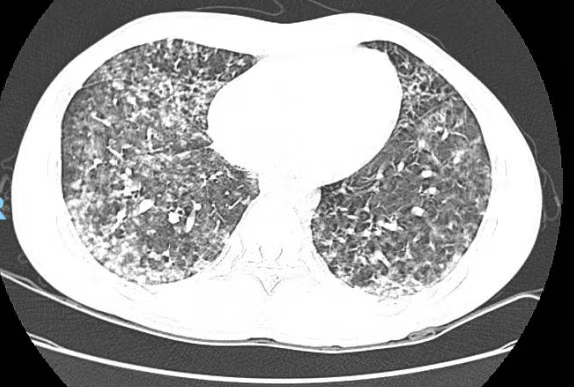

夏日炎炎,许多朋友喜欢到野外玩水游泳消暑。家住广州番禺的文先生(化名)和家人去郊外度假时,文先生不慎滑倒,导致右侧肘关节出现皮肤破损。他当时并没有太在意,而是被周围美丽的自然风光吸引,忍不住畅游一番。

右侧肘关节皮损
然而,回家后不久,文先生就开始发烧,由于家人近期也有感冒症状,他误以为自己也是感冒,并未及时就医。随后,他出现了畏寒、乏力、全身肌肉酸痛、腹泻等症状,体温一度飙升到39℃,并伴有呼吸困难和痰中带血。

文先生意识到情况不妙,急忙前往广州医科大学附属番禺中心医院急诊就诊。经过紧急检查,医生发现他的氧合指数差,感染相关指标显著升高,同时出现了肝、肾功能损伤、血小板下降和凝血功能异常等多脏器功能损害。胸部CT显示双肺多发感染性病变,病情危急,他被立即收入重症医学科进行治疗。
患者胸部CT显示双肺多发感染性病变
在重症医学科,治疗团队迅速给予文先生重症监护、高流量氧疗和清醒俯卧位通气,并进行了纤维支气管镜检查和肺泡灌洗,以完善病原学筛查。肺泡灌洗液的靶向测序结果显示感染了肾脏钩端螺旋体。在明确病因后,治疗团队立即调整了治疗方案。经过一段时间的精心治疗,文先生的病情迅速好转,最终顺利转出重症医学科。

患者转出重症医学科时与医护人员合影
医生提醒,钩端螺旋体病是我国法定乙类传染病,由多种致病性钩端螺旋体引起,属于人畜共患病,常见传染源为鼠类和猪。我国大部分地区都有本病的散发或流行。人通过破损的皮肤或黏膜接触被染有钩端螺旋体的疫水是感染本病的主要途径。近期雨水增多、洪水泛滥,增加了感染的风险。

感染钩端螺旋体后,患者会出现发热、头痛、肌肉酸痛、全身乏力、眼结膜充血和全身浅表淋巴结肿大等症状。重症患者可能出现严重的肝、肾、中枢神经系统损害和肺弥漫性出血,危及生命。专家提醒,若皮肤有伤口且近期接触过污水,一旦出现高热、咳血、小腿痛等症状,应立即就医,以免错过最佳治疗时机,危及生命。
文、图/广州日报新花城记者:肖桂来 通讯员:冯劲伦
广州日报新花城编辑:何钻莹
























































